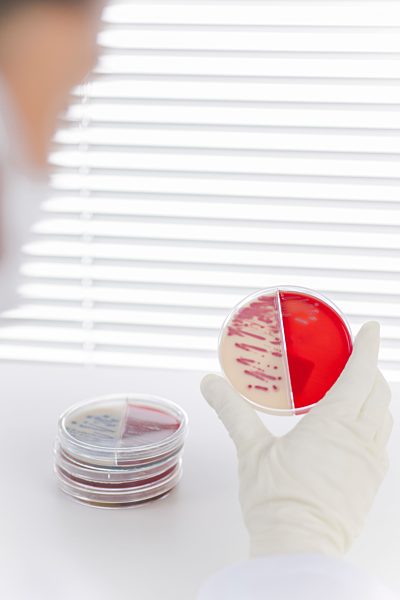
Laboratory technician examining agar plate with bacteria

Gut beraten: Recht & Wirtschaft

18.12.2015 - ILLUSTRATION - Ein Maschendrahtzaun vor den Sternen der Europaflagge, aufgenommen am 18.12.2015. Foto: S. Steinach - ACHTUNG! KEINE BILDFUNKVERWENDUNG -
65424449

06.10.2011 - ILLUSTRATION: Eine Frau zereisst ihr Hochzeitsfoto, aufgenommen in Frankfurt (Oder) am 06.10.2011 (Symbolbild zum Thema Scheidung). Im Jahr 2010 wurden 11 von 1000 Ehen getrennt. D...
27346784

11.02.2015 - ILLUSTRATION - Buchstabenwürfel ergeben die Worte "mehr Netto vom Brutto", aufgenommen am 11.02.2015. Foto: /Steinach - ACHTUNG! KEINE BILDFUNKVERWENDUNG -
58058775

01.06.2015 - ILLUSTRATION - Würfel liegen auf Geldscheinen, aufgenommen am 01.06.2015 in Dresden (Sachsen). Foto: Thomas Eisenhuth
58893714

13.05.2015 - ILLUSTRATION - Geld liegt am 13.05.2015 neben einer Kaffeetasse und einem Kassenzettel auf einem Tisch in einem Café in Berlin. Foto: Sonja Marzoner/dpa
58295167

24.03.2016 - ILLUSTRATION - Die Modellfiguren eines Rentnerpaares auf einer Bank sitzend stehen am 24.03.2016 in Potsdam (Brandenburg) auf einem Stapel Münzen. In Westdeutschland steigt die Ren...
66942989

07.09.2016 - ILLUSTRATION - Die Zentrale der Europäischen Zentralbank (EZB) in Frankfurt am Main (Hessen) spiegelt sich am 07.09.2016 in einem Spiegel. Europas oberste Währungshüter treffen sic...
83497842

07.02.2017 - Euro coin money rain
89092920

02.07.2015 - Euro Münze wird vom Blitz getroffen.
59854909

16.10.2015 - Verschärfung des Asylrechts anlässlich des anhaltenden Zustrom s an Flüchtlingen nach Deutschland und Europa auf Bearbeitung des Asylantrag s und Anerkennung wartende Miniatur Figu...
63700781

31.10.2008 - Managerpuppe vor EKG-Kurve | manager-doll with ECG
51149165

05.05.2015 - Car tyre in wetness
59543967

13.01.2017 - Ein Auto fährt im Schneetreiben auf einer verschneiten Strasse, aufgenommen am 13.01.2017. Foto: Frank May/picture alliance
87192128

10.09.2015 - ILLUSTRATION - Eine junge Frau sitzt am 10.09.2015 in Berlin in einem Buero und schaut auf einen kleinen Globus. Foto: Christin Klose
80711956

01.11.2005 - Low angle view of a bride holding a bouquet of flowers
29685517

30.03.2011 - Schmuck und Handtasche
89423120

28.05.2017 - Abstract pattern of wind and wind turbines
93179884

26.08.2011 - Geschäftsmänner auf einem Winkelmesser mit Bleistift
41903105

01.01.1000 - Crane control booth frame against morning sky
93315049

13.02.2014 - Human hand and animal paw united under drawing of the Earth
56440473

25.02.2015 - Detail of a chain made of chromed steel
58760328

02.07.2015 - Euro Geldscheine und Kurve mit Devisenkurs
59854898

21.07.2015 - Große Anzahl gerollter einhundert Euro Banknoten.
60231905

09.03.2015 - Gruener Umschlag mit Flugzeugen auf blauem Hintergrund
58040150

24.10.2008 - Symbolbild, Pharmazeut erklaert den Inhalt einer geoeffneten Tablettenkapsel | druggist explaning his medicament
51134452

11.04.2014 - Symbolbil Ungleichgewicht bei Rentenentwicklung in Ost und West Senioren stehen auf unterschiedlich hohen Muenzstapeln von Euro Geldmuenzen und Euro Symbol
55584350

27.05.2007 - Deutschland, Hamburg, 27.05.2007, Das Wort "HARTZ IV" in Nahaufnahme in einer manuellen Schreibmaschine
87842478

22.05.2015 - Symbolical picture for enewable energies
60254868

22.06.2016 - Map and letters go somewhere
83422894

01.01.2000 - Man talking on the phone connected to tangled red line
93180040

04.11.2008 - 'DAX' aus Buchstabenwuerfeln gesetzt | 'DAX' set by letter dice
51157440

21.01.2013 - Stacks of Euro coins with One Cent coin, close up
52634795

18.11.2009 - Soziale Schere, Kluft zwischen Arm und Reich
16931422

01.01.1000 - An Infant Coffin In A Church
24621896

27.08.2014 - Germany, Schleswig-Holstein, Kiel, Jetty, rope on poller
56440594

22.02.2013 - White bunny wearing human glasses on white background
54662887

31.03.2011 - Empty rectangular speech bubble on a blackboard
54688783

16.01.2014 - IMA-Internationale Fachmesse Unterhaltungs- und Warenautomaten, Düsseldorf , Deutschland , Messehallen 8 A und 8 B in Düsseldorf ,Messegelände vom
14. - 17. 01. 2014
Dartscheibe e...
45603640

04.11.2008 - 'Aktien' aus Buchstabenwuerfeln gesetzt | 'Aktien' set by letter dice
51150263

28.01.2009 - Kreditvertrag mit Justizhammer | credit agreement with justice hammer
51160618

05.07.2012 - Dartscheibe | dart board
44990573

10.11.2014 - Boy and girl sitting and reading under book tree
56458794

01.01.1000 - Germany, Dandelions with garbage truck and workers in background
52424163

15.01.2013 - Figurine in wheelchair near paragraph sign
52616176

12.06.2012 - Miniature house on a log
41751690

08.06.2012 - A dart stuck in the bull's eye of a miniature archery target
35068672

26.12.2011 - Four Leaf Clover, Close-Up View
41751394

01.01.2000 - Data and communications collage
93179637

13.06.2015 - 3D Rendering, paper clips holding hands
60254440

14.01.2016 - Cactus on a white background
83426901

24.02.2016 - Beluga lentils on plate shaped like a world map
83426882

25.02.2015 - Woman's hand cleaning glass pane
57307108

28.04.2010 - viele Euromuenzen im Glaskrug | many euro coins in glass mug
51157356

25.05.2012 - Glass globe
41751860

17.05.2011 - Ladybug On Four Leaf Clover
41751391

27.02.2016 - ILLUSTRATION - Das Wort Erbe, aufgenommen am 27.02.2016 in Osterode am Harz. Foto: Frank May/picture alliance
65388794

15.10.2008 - DAX unter der Lupe | DAX under the magnifying glass
51143100

23.12.2011 - Couple standing apart in sea with backs turned toward each other
29604905

13.11.2006 - Frayed rope
29679347

13.11.2006 - Two stands of wool tied together
29676444

02.10.2009 - A group of wind turbines standing next to a road in a moorland landscape on the coast at dawn.
90349546

10.08.2007 - Shadow of a man and a woman holding hands
29732544

04.09.2010 - Archery target with arrow in the centre
63963035

24.12.2015 - Symbolbild Kindergeld und Erziehungsgeld in Deutschland Miniatur Figur einer Mutter mit ihrem Baby auf dem Arm auf Euro Geldscheinen
67055352

01.01.2000 - Data, graph paper and shapes in abstract geometric pattern
93179718

24.04.2017 - Man adding cog to pile using forklift truck
93179202

08.06.2012 - A target with a blurred focus except in the bull's eye
35067778

27.02.2016 - ILLUSTRATION - Das Wort Erbe, aufgenommen am 27.02.2016 in Osterode am Harz. Foto: Frank May/picture alliance
65388783

27.09.2013 - Open suitcase on bed with wedding figurines
50680521
21.02.2015 - Laboratory technician examining agar plate with bacteria
58032551

29.11.2013 - Hand putting coin into piggy bank and coins flowing out
50697514

12.06.2012 - Glass globe
41751712

16.05.2011 - Ladybug On Four Leaf Clover
41751389

01.01.1000 - Young woman holding paper cutouts, portrait
52503102

01.02.2008 - Two human hands holding fencing foils in confrontation
29676723

23.04.2013 - Junge Pflanze spriesst aus Erde
89423176

23.09.2013 - Bunte Chemikalien in einem Labor
82442897

14.03.2012 - Sunlight through fingers, cropped
41720957

31.10.2008 - EKG Kurve, Elektrokardiogramm | EKG Kurve / ECG
51145939

12.06.2012 - Glass globe
41751691

06.02.2016 - Figurines on mountain peaks
83423973

25.02.2014 - Abstraktes Muster überlappender Zielscheiben
56469882

10.01.2011 - Seniorenpaar auf Sofa streitet sich, Ganzkörperansicht
25575393

05.11.2008 - 'Geld' aus Buchstabenwuerfeln gesetzt | 'Geld' set by letter dice
51134813

22.10.2008 - Symbolbild Bausparen, Euromuenzen formen ein Haus | To save with a building society
51151715

02.07.2015 - Viele fliegende Euro Geldscheine
59854924

18.07.2008 - Auto und Euros | car and Euros
51161860
Haben Sie noch nicht gefunden, was Sie suchen? Registrieren oder melden Sie sich an, um Zugriff auf eine größere Auswahl an Bildern zu erhalten und unser volles Angebot an Bildern, Videos und Grafiken zu nutzen.
Sie haben Fragen?
Haben Sie Fragen oder wünschen individuelle Beratung? Unser Team ist jederzeit für Sie da.
Verkauf / Lizenzierung
Bei Fragen rund um das Thema Lizenzierung









